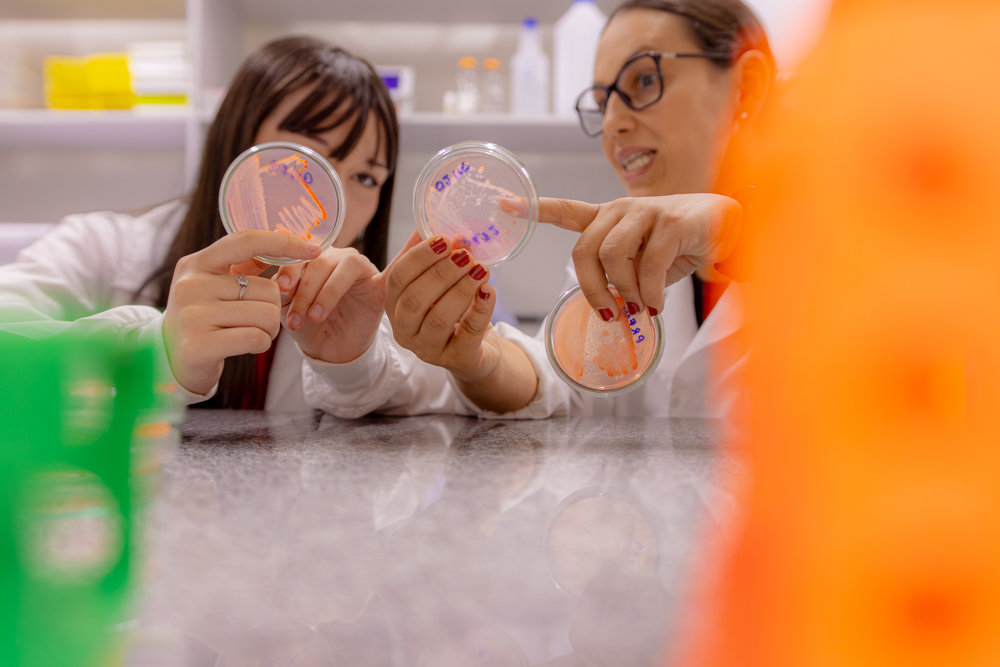
Foto: Reprodução/UEPG

Na sala de aula, laboratório ou no corredor, o olhar é de admiração – seja de quem ainda é estudante do Ensino Médio ou da pesquisadora de carreira do ensino superior. Nesta quarta-feira (11), a Universidade Estadual de Ponta Grossa (UEPG) celebra o Dia Internacional das Mulheres e Meninas na Ciência, com professoras e alunas que pesquisam pelo Programa Institucional de Iniciação Científica Júnior (Pibic-Jr), produzem ciência e inspiram pessoas a vislumbrar um futuro com mais representatividade. 
A UEPG entende de espaços ocupados por elas: são professoras que orientam alunos de iniciação científica e 20 que estão no Pibic-Jr. Dentre elas, há uma dupla que busca conhecer os microorganismos: a professora Jesiane Batista e a aluna Sofia Petuba Nascimento atuam no Laboratório de Biodiversidade, no Bloco M. Depois do “boa tarde” efusivo, de quem anda sempre atarefada, a docente já passa as atividades do dia para a orientanda. A dupla investiga a diversidade microbiana nas rochas do Parque Estadual de Vila Velha, realizando isolamento de bactérias a partir de amostras. Sofia prepara e analisa os materiais e trabalha no mesmo ambiente que alunos da graduação até o Doutorado. “Às vezes, é meio louco pensar que eu tão nova já estou fazendo parte deste ambiente, que é mais adulto. É muito legal colocar em prática e aprofundar algumas coisas que eu aprendo na escola”, conta. No laboratório, Sofia presta atenção às orientações de Jesiane, enquanto manuseia uma placa de petri na capela de exaustão. Para a professora, a atividade é um meio de popularização da ciência.
“Entender como a ciência funciona é importante para todas as pessoas, independentemente do desejo de seguir na carreira científica ou não”, enfatiza Jesiane. Enquanto Sofia afirma que quer seguir na Psicologia depois do Ensino Médio, Jesiane destaca que entender o método científico desde cedo é uma influência positiva para pesquisadores de qualquer área do conhecimento.
E sobre orientar uma menina que ainda não chegou na graduação? Jesiane sorri: “É um desafio, mas estamos em um ambiente com pessoas que realizam TCC, Iniciação Científica, Mestrado e Doutorado. E isso é muito bom para os Pibic-Jr, pois a gente vê que eles chegam com aquela curiosidade de aprender sobre ciência, isso é muito gratificante”. Para Sofia, a figura da professora Jesiane inspira respeito e um modelo de como ser mulher pesquisadora. “Ah, ela é um exemplo pra mim, como professora e como mulher. Tanto a Jesiane quanto a minha mãe são modelos que eu respeito demais”, conta a aluna.

De mãe para filha

Pelos olhos da mentora, Maria Clara é muito dedicada e organizada. “Tenho cinco orientandos Pibic-Jr, e ela é a única menina. Tanto é que quando foi para dar bolsa [de pesquisa], eu falei: ‘Não tenho dúvida, minha bolsa vai para uma menina’, e é isso, a experiência tem sido muito boa”. Para Sofia, que já conhece os corredores da Universidade, pois já participou de várias edições das Olimpíadas de Matemática, realizar o Pibic-Jr com a professora Petuba é sinônimo de se sentir à vontade. “Ela é uma ótima professora, consigo conversar sobre meu trabalho com ela de boa e falar tudo o que eu preciso. É uma professora muito gente boa”.



Tudo muda quando se é mulher

Uma confiança mútua. É assim que a dupla define a relação na pesquisa. “Olha, eu sou meio introvertida e tenho vergonha de falar, mas com a professora Natasha eu consegui me abrir e vejo ela muito como a minha mãe, porque eu lembro de ver a minha mãe trabalhando quando eu era pequena e agora ver a Natasha trabalhando me inspira muito, foi a pessoa com quem eu consegui me abrir de verdade por aqui”. Por falar em maternidade – e longe de resumir a atuação de uma pesquisadora à ser mãe – Natasha destaca o ponto crucial que é para ela trabalhar e ter uma filha pequena em casa: “a maternidade é uma realidade de muitas de nós, professoras, e isso é um ponto de intersecção. Temos que sempre estar equilibrando vários pratos, então é uma realidade bem desafiadora”. Ver o dia a dia de uma professora universitária é positivo para as futuras cientistas, segundo a docente. “Acho que é muito necessário que projetos como o Pibic-Jr continuem e inspirem cada vez mais alunas”.



Sobre ocupar espaços

Embora sejam áreas do conhecimento distintas, o olhar das entrevistadas sobre a pesquisa realizada por mulheres e meninas é basicamente o mesmo: a importância de ocupar espaços. “Ter mulheres em lugares de liderança, na parte administrativa, na sala de aula ou no laboratório é ter alguém que as meninas vão olhar e pensar ‘eu também consigo’. Ocupar espaços é trazer à tona assuntos que são importantes para nós e que antes não eram falados, por isso da importância de projetos como esse”, enfatiza Jesiane. Quando se é mulher na ciência, sempre haverá um desafio: “seja porque você é mãe, ou é jovem demais, ou velha demais, sempre haverá alguém que irá questionar o porquê de você estar ali, por isso da importância de estar em lugares de decisão”, explica Natasha. 
Duplamente orgulhosa pela filha e pela orientanda, quando perguntada o que é ser uma mulher na ciência, a professora Petuba suspira, sorri e finaliza: “É construir um conhecimento mais democrático, entender que as mulheres contribuem para o fortalecimento do país, da nação, e eu acho que o mais fundamental mesmo para a gente é inspirar outras mulheres, inspirar outras meninas, inspirar as nossas filhas, inspirar as nossas alunas”.
Texto e fotos: Jéssica Natal
São Paulo Carnaval 2026 nas regiões de Barretos e São José do Rio Preto tem opções para todos os foliões
Sergipe Convite à imprensa: Governo de Sergipe institui Escola Estadual do SUAS para qualificação permanente da assistência social
Acre Governo estabelece pontos facultativos no período de Carnaval e mantém serviços essenciais
Legislativo - MS Crimes contra crianças motivam pedido por delegacia especializada em Dourados
Caruaru - PE Aulão de Dança Pré-Carnaval transforma a Estação Ferroviária em palco de saúde e alegria em Caruaru
Piauí Protagonista nacional na abertura de negócios, Piauí registra crescimento recorde com 38.982 novas empresas
Acre Governança do Sisa realiza primeira reunião extraordinária de 2026 e reforça planejamento participativo
Desenvolviment... Monitoramento ambiental garante requalificação eficiente da orla de Pontal do Paraná
Caruaru - PE Prefeitura de Caruaru dá início a obras na Avenida João Soares de Lira; investimento é de R$ 2,7 milhões Mín. 19° Máx. 31°





